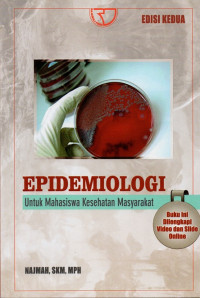
Image of Epidemiologi : untuk mahasiswa kesehatan masyarakat

Epidemiologi : untuk mahasiswa kesehatan masyarakat
Buku epidemiologi : untuk mahasiswa kesehatan masyarakat - buku ini dilengkapi dengan video dan slide online berisi tentang epidemiologi dasar, perhitungan dalam epidemiologi, standarisasi dalam epidemiologi, memahami konsep faktor perancu, skrining/penapisan dalam epidemiologi, studi desain dalam epidemiologi, aperhitungan sampel dalam penelitian epidemiologi, surveilans dalam epidemiologi, telaah kritis penelitian observasional epidemiologi, telaah kritis penelitian eksperimental epidemiologi.
Ketersediaan
#
Perpustakaan Terpadu Polkestan
614.4 NAJ E c.3
01766.3
Tersedia
#
Perpustakaan Terpadu Polkestan
614.4 NAJ E c.2
01766.2
Tersedia
#
Perpustakaan Terpadu Polkestan
614.4 NAJ E c.1
01766
Tersedia namun tidak untuk dipinjamkan - No Loan
#
Perpustakaan Terpadu Polkestan
614.4 NAJ E c.4
01766.4
Tersedia
#
Perpustakaan Terpadu Polkestan
614.4 NAJ E c.5
01766.5
Tersedia
#
Perpustakaan Terpadu Polkestan
614.4 NAJ E c.6
01766.6
Tersedia
#
Perpustakaan Terpadu Polkestan
614.4 NAJ E c.7
01766.7
Tersedia
#
Perpustakaan Terpadu Polkestan
614.4 NAJ E c.8
01766.8
Tersedia
#
Perpustakaan Terpadu Polkestan
614.4 NAJ E c.9
01766.9
Tersedia
#
Perpustakaan Terpadu Polkestan
614.4 NAJ E c.10
01766.10
Tersedia
#
Perpustakaan Terpadu Polkestan
614.4 NAJ E c.11
01766.11
Tersedia
#
Perpustakaan Terpadu Polkestan
614.4 NAJ E c.12
01766.12
Tersedia
#
Perpustakaan Terpadu Polkestan
614.4 NAJ E c.13
01766.13
Tersedia
#
Perpustakaan Terpadu Polkestan
614.4 NAJ E c.14
01766.14
Tersedia
#
Perpustakaan Terpadu Polkestan
614.4 NAJ E c.15
01766.15
Tersedia
#
Perpustakaan Terpadu Polkestan
614.4 NAJ E c.16
01766.16
Tersedia
#
Perpustakaan Terpadu Polkestan
614.4 NAJ E c.17
01766.17
Tersedia
#
Perpustakaan Terpadu Polkestan
614.4 NAJ E c.18
01766.18
Tersedia
#
Perpustakaan Terpadu Polkestan
614.4 NAJ E c.19
01766.19
Tersedia
#
Perpustakaan Terpadu Polkestan
614.4 NAJ E c.20
01766.20
Tersedia
#
Perpustakaan Terpadu Polkestan
614.4 NAJ E c.21
01766.21
Tersedia
#
Perpustakaan Terpadu Polkestan
614.4 NAJ E c.22
01766.22
Tersedia
#
Perpustakaan Terpadu Polkestan
614.4 NAJ E c.23
01766.23
Tersedia
#
Perpustakaan Terpadu Polkestan
614.4 NAJ E c.24
01766.24
Tersedia
Informasi Detail
- Judul Seri
-
-
- No. Panggil
-
614.4 NAJ E
- Penerbit
- Depok : Rajawali Pers., 2019
- Deskripsi Fisik
-
xxviii, 246 hlm.: ilus.; 23 cm.
- Bahasa
-
Indonesia
- ISBN/ISSN
-
978-602-425-052-2
- Klasifikasi
-
614.4
- Tipe Isi
-
-
- Tipe Media
-
-
- Tipe Pembawa
-
-
- Edisi
-
Edisi 2
- Subjek
- Info Detail Spesifik
-
Bibliografi : hlm. 25, 49, 73, 94, 113, 138, 167, 186, 205, 229.
- Pernyataan Tanggungjawab
-
-
Versi lain/terkait
Tidak tersedia versi lain
Lampiran Berkas
Tidak Ada Data
Komentar
Anda harus masuk sebelum memberikan komentar
Karya Umum
Karya Umum  Filsafat
Filsafat  Agama
Agama  Ilmu-ilmu Sosial
Ilmu-ilmu Sosial  Bahasa
Bahasa  Ilmu-ilmu Murni
Ilmu-ilmu Murni  Ilmu-ilmu Terapan
Ilmu-ilmu Terapan  Kesenian, Hiburan, dan Olahraga
Kesenian, Hiburan, dan Olahraga  Kesusastraan
Kesusastraan  Geografi dan Sejarah
Geografi dan Sejarah